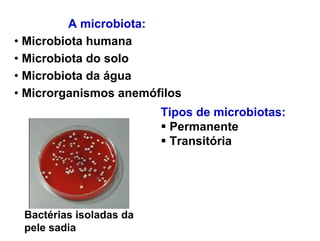
A microbiota:
• Microbiota humana
• Microbiota do solo
• Microbiota da água
• Microrganismos anemófilos
                         Tipos de microbiotas:
                          Permanente
                          Transitória




 Bactérias isoladas da
 pele sadia

O documento discute a importância e classificação de microrganismos. Apresenta os principais tipos de microrganismos e suas funções, incluindo sua participação em processos como produção de alimentos e medicamentos, degradação de compostos, controle biológico de pragas e doenças. Também resume as principais classificações de microrganismos de acordo com Whittaker e Woese.

![Classificação dos microrganismos
Domínio Eubacteria: bactérias verdadeiras, possuem parede
- Gram positivas
- Gram negativas
- Mycoplasmas
- Cianobactérias (algas X bactérias) bactérias fotossintetizantes
Domínio Eucaria: todos os eucariotos. Núcleo verdadeiro
- Unicelula: amebas, leveduras
- Multicelular: fungos, plantas, animais
Domínio Archae: origem 4 bilhões de anos
são formas primitivas, encontradas em ambientes hostis
- Extremófilas (termófilos – Termophylus aquatticus –Taq DNA polimerase)
Pyrococcus – gêiser e águas termais
- Metanogênicas (ambientes como pântanos, ricos em gás metano)
- Acidúricas: ambientes ácidos
- Halófilas: alta [ ] de sal, salinas](https://image.slidesharecdn.com/aula1introducao-121003052935-phpapp01/85/Aula-1-introducao-a-microbiologia-17-320.jpg)
